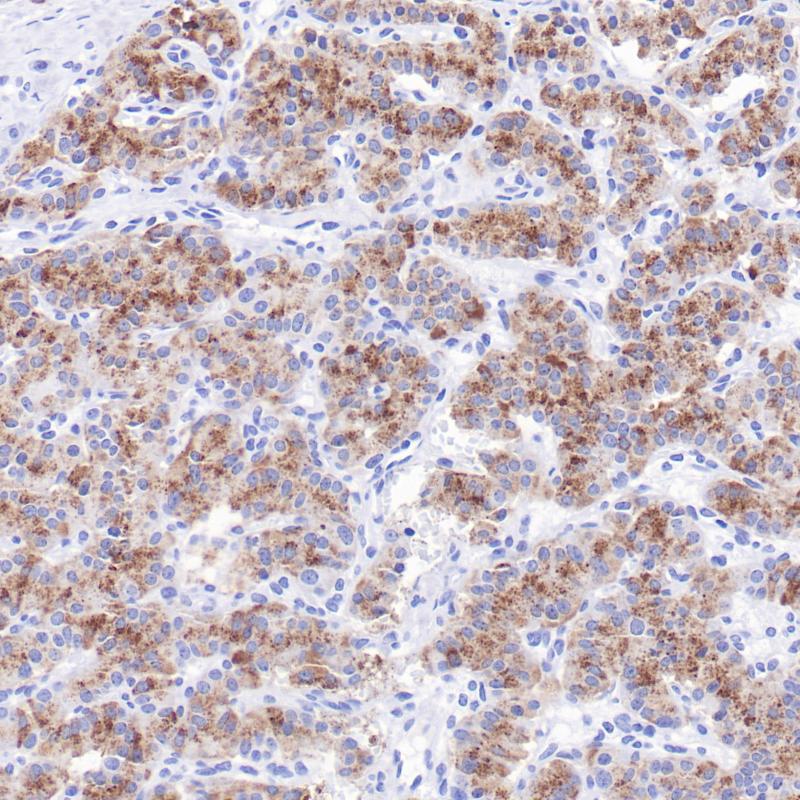
胰岛素瘤C-Peptide(BP6326)染色

产品中心
胰岛素瘤C-Peptide(BP6326)染色
C-Peptide 重组兔单克隆抗体
C-Peptide(C肽)是含31个氨基酸的多肽,由胰岛素原裂解产生,一分子胰岛素原产生一分子C 肽与一分子的A、B 链,后二者合成胰岛素。C肽主要在胰岛β细胞中表达,在葡萄糖刺激下,它与胰岛素以等摩尔比例一同分泌。在胰腺组织中对C肽的免疫组化是定位胰岛β细胞、鉴别胰岛素分泌性肿瘤、评估胰腺内分泌功能的核心病理标志物,主要用于胰腺肿瘤与胰岛病变的诊断与分型。
Specifications
- 目录号
- BX50358
- 克隆号
- BP6326
- 阳性对照
- 胰岛素瘤
- 亚细胞定位
- Secreted
- 组织类型
- FFPE
- 修复方式
- HIER
- 稀释比
- 1:100-1:200
- 规格
- 100μl/vial, 1ml/vial
- 用途
- RUO
Reference
1. Chen, J. et al. (2023) Front Endocrinol (Lausanne)14:1256093.
2. Jones, AG. et al. (2013) Diabet Med 30(7):803-17


